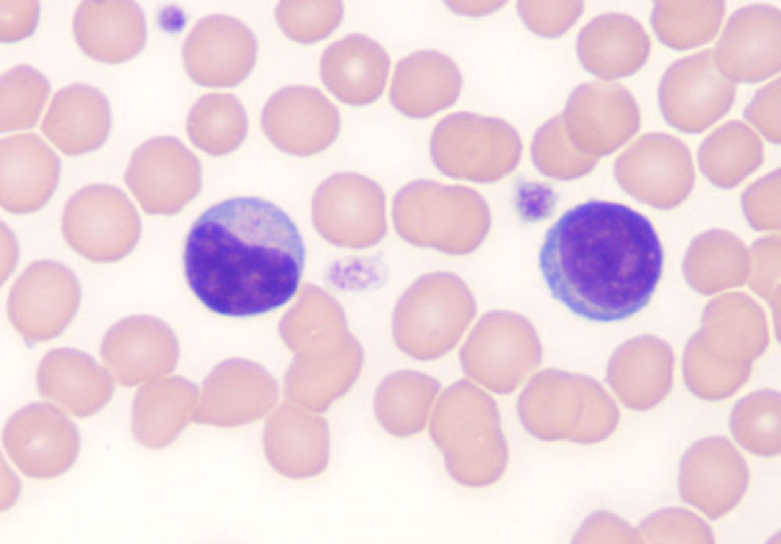

Imagine having an on-demand massage just the way you like it, whenever you need one? That feel-good, calm and peaceful feeling can last for several hours. But the benefits of regular massage don’t stop there. Regular massage has a clinically proven, positive and lasting impact on your health and wellbeing.
Today the technology in massage chairs has become so advanced that it is able to detect and map the contours of your body, providing a massage customised to your specific needs. Having a massage chair at home is like having your own personal masseur available 24×7. Just 20-30 minutes a day gives you plenty of wonderful health benefits.
Let’s discover them below.
 Research studies such as Delaney’s Short-term effects of myofascial trigger point massage therapy on cardiac autonomic tone in healthy subjects and Cady’s Massage therapy as a workplace intervention for reduction of stress have shown that massage therapy alleviates symptoms of stress and tension in the body.
Massage therapy reduces stress on physical and psychological levels and supports the parasympathetic nervous system which is responsible for relaxing the body and conserving energy. Blood pressure and cortisol levels (the stress hormone) were all lower after a 10 to 15 minute chair massage in these controlled studies.
In Australia, where stress accounts for $14B in lost productivity per year, a massage chair at home is a simple solution for anyone who wants to ease stress and tension in their mind and body at the end of the day.
Research studies such as Delaney’s Short-term effects of myofascial trigger point massage therapy on cardiac autonomic tone in healthy subjects and Cady’s Massage therapy as a workplace intervention for reduction of stress have shown that massage therapy alleviates symptoms of stress and tension in the body.
Massage therapy reduces stress on physical and psychological levels and supports the parasympathetic nervous system which is responsible for relaxing the body and conserving energy. Blood pressure and cortisol levels (the stress hormone) were all lower after a 10 to 15 minute chair massage in these controlled studies.
In Australia, where stress accounts for $14B in lost productivity per year, a massage chair at home is a simple solution for anyone who wants to ease stress and tension in their mind and body at the end of the day.
 There are two features of a massage chair that assist with improved blood circulation.
The first feature is the mechanised massage techniques which include kneading, rolling, tapping, gripping, and Shiatsu. In all these techniques, the rollers of massage chairs move and vibrate over key points in the body to stimulate and improve blood flow.
There are several benefits from boosting your blood circulation. These include:
There are two features of a massage chair that assist with improved blood circulation.
The first feature is the mechanised massage techniques which include kneading, rolling, tapping, gripping, and Shiatsu. In all these techniques, the rollers of massage chairs move and vibrate over key points in the body to stimulate and improve blood flow.
There are several benefits from boosting your blood circulation. These include:
 Did you know that a 45-minute massage increases the number of lymphocytes in the body? Lymphocytes are white blood cells that help defend the body against diseases. They are responsible for the body’s immune response and prevent everyday problems like the common cold, fever, or flu.
According to experts, just one massage is enough to produce enough lymphocytes and measure significant quantifiable changes to the body’s endocrine and immune response.
Did you know that a 45-minute massage increases the number of lymphocytes in the body? Lymphocytes are white blood cells that help defend the body against diseases. They are responsible for the body’s immune response and prevent everyday problems like the common cold, fever, or flu.
According to experts, just one massage is enough to produce enough lymphocytes and measure significant quantifiable changes to the body’s endocrine and immune response.
 The massage action of massage chairs in the reclined position stimulates the lymphatic system and helps to move lymph through the body, combating inflammation and disease. This position also elevates the feet above the heart which is common solution to reduce swelling.
The massage action of massage chairs in the reclined position stimulates the lymphatic system and helps to move lymph through the body, combating inflammation and disease. This position also elevates the feet above the heart which is common solution to reduce swelling.
 Massage chairs have a proven track record of alleviating all sorts of pain including headaches, common body aches, chronic neck, shoulder or back pain and more. Studies show that massage therapy decreases cortisol levels (the stress hormone) and increases serotonin by an average of 28%. Serotonin is the body’s feel good hormone and one of the body’s anti-pain mechanisms. By lowering cortisol and increasing serotonin, the body is better able to manage pain.
While most, if not all massage chairs have the potential to ease regular pain, specialised massage chairs are designed to do so. Pain is relieved through a variety of massage programs and body-heating action.
Testimonies from pain sufferers have shown that massage chairs either significantly reduced chronic pain or have eliminated it completely. This is a great benefit for an ageing population or people who may be managing chronic pain. Massage chairs offer a cheaper alternative to expensive physical therapies and gadgets.
For people who have been suffering from pain for a long time, this is the most compelling of all massage chair benefits.
Massage chairs have a proven track record of alleviating all sorts of pain including headaches, common body aches, chronic neck, shoulder or back pain and more. Studies show that massage therapy decreases cortisol levels (the stress hormone) and increases serotonin by an average of 28%. Serotonin is the body’s feel good hormone and one of the body’s anti-pain mechanisms. By lowering cortisol and increasing serotonin, the body is better able to manage pain.
While most, if not all massage chairs have the potential to ease regular pain, specialised massage chairs are designed to do so. Pain is relieved through a variety of massage programs and body-heating action.
Testimonies from pain sufferers have shown that massage chairs either significantly reduced chronic pain or have eliminated it completely. This is a great benefit for an ageing population or people who may be managing chronic pain. Massage chairs offer a cheaper alternative to expensive physical therapies and gadgets.
For people who have been suffering from pain for a long time, this is the most compelling of all massage chair benefits.
 People suffering from trigger points and spasm areas experience relief and restoration from regular massage therapy. Tense muscles and ‘knots’ are loosened over time.
Research findings from the Buck Institute for Research on Aging in Ontario showed that massage decreases inflammation and even promotes the growth of new mitochondria, the body’s powerhouse on a cellular level.
People suffering from trigger points and spasm areas experience relief and restoration from regular massage therapy. Tense muscles and ‘knots’ are loosened over time.
Research findings from the Buck Institute for Research on Aging in Ontario showed that massage decreases inflammation and even promotes the growth of new mitochondria, the body’s powerhouse on a cellular level.
 The feeling of total relaxation and wellbeing helps to keep blood pressure down. Similar to the effects of finishing a good run or a yoga workout, your blood pressure lowers, and your heart rate slows after a massage. We can go on about how the body responds to lower blood pressure, but the best proof is to get on a massage chair and experience the “total relaxation” experience.
The feeling of total relaxation and wellbeing helps to keep blood pressure down. Similar to the effects of finishing a good run or a yoga workout, your blood pressure lowers, and your heart rate slows after a massage. We can go on about how the body responds to lower blood pressure, but the best proof is to get on a massage chair and experience the “total relaxation” experience.

 In studies of women with Stages 1 and 2 breast cancer, it was found that women who had a 30-minute massage, three times a week for five consecutive weeks, reduced feelings of depression and agitation. Their urine results also showed increased levels of dopamine, serotonin, NK cells, and lymphocytes. Not only did their overall mood improve, but their immune systems also received a boost.
According to research, adults who have a 15-minute session in a massage chair twice a week, every week for five consecutive weeks experienced an increase in delta waves and a decrease in alpha waves.
Delta waves are the deep sleep waves while alpha waves are the waking and reasoning waves. Massage chair therapy helped the adults fall into either a deep relaxation state or a light sleeping state while decreasing conscious anxiety.
In studies of women with Stages 1 and 2 breast cancer, it was found that women who had a 30-minute massage, three times a week for five consecutive weeks, reduced feelings of depression and agitation. Their urine results also showed increased levels of dopamine, serotonin, NK cells, and lymphocytes. Not only did their overall mood improve, but their immune systems also received a boost.
According to research, adults who have a 15-minute session in a massage chair twice a week, every week for five consecutive weeks experienced an increase in delta waves and a decrease in alpha waves.
Delta waves are the deep sleep waves while alpha waves are the waking and reasoning waves. Massage chair therapy helped the adults fall into either a deep relaxation state or a light sleeping state while decreasing conscious anxiety.

1. Reduces stress, tension, and anxiety
 Research studies such as Delaney’s Short-term effects of myofascial trigger point massage therapy on cardiac autonomic tone in healthy subjects and Cady’s Massage therapy as a workplace intervention for reduction of stress have shown that massage therapy alleviates symptoms of stress and tension in the body.
Massage therapy reduces stress on physical and psychological levels and supports the parasympathetic nervous system which is responsible for relaxing the body and conserving energy. Blood pressure and cortisol levels (the stress hormone) were all lower after a 10 to 15 minute chair massage in these controlled studies.
In Australia, where stress accounts for $14B in lost productivity per year, a massage chair at home is a simple solution for anyone who wants to ease stress and tension in their mind and body at the end of the day.
Research studies such as Delaney’s Short-term effects of myofascial trigger point massage therapy on cardiac autonomic tone in healthy subjects and Cady’s Massage therapy as a workplace intervention for reduction of stress have shown that massage therapy alleviates symptoms of stress and tension in the body.
Massage therapy reduces stress on physical and psychological levels and supports the parasympathetic nervous system which is responsible for relaxing the body and conserving energy. Blood pressure and cortisol levels (the stress hormone) were all lower after a 10 to 15 minute chair massage in these controlled studies.
In Australia, where stress accounts for $14B in lost productivity per year, a massage chair at home is a simple solution for anyone who wants to ease stress and tension in their mind and body at the end of the day.
2. Relaxes and loosens sore muscles
The human body is intelligent. When you overexert your body beyond what is healthy for you, the muscles stiffen and become sore. These signals are designed to stop you from causing any further damage to tendons and muscles. Spending 20-minutes in a massage chair in your home is not just a beautiful way to relax, it will help your muscles settle back into their natural state. Massage loosens sore and fatigued muscles, and releases tension in your body, especially with the Shiatsu mode which is a feature in our chairs. After a long and hard day at work, whether you’re working outdoors, in an office, or with the kids, we can guarantee that sitting on one of our chairs for 20-minutes will help you to release the tension of the day.3. Improves blood flow
 There are two features of a massage chair that assist with improved blood circulation.
The first feature is the mechanised massage techniques which include kneading, rolling, tapping, gripping, and Shiatsu. In all these techniques, the rollers of massage chairs move and vibrate over key points in the body to stimulate and improve blood flow.
There are several benefits from boosting your blood circulation. These include:
There are two features of a massage chair that assist with improved blood circulation.
The first feature is the mechanised massage techniques which include kneading, rolling, tapping, gripping, and Shiatsu. In all these techniques, the rollers of massage chairs move and vibrate over key points in the body to stimulate and improve blood flow.
There are several benefits from boosting your blood circulation. These include:
- Speeding up recovery from injuries and ailments
- Eliminating toxins from the body
- Stimulation of endorphins that help the body cope with pain and stress.
4. Boosts immune system
Did you know that a 45-minute massage increases the number of lymphocytes in the body? Lymphocytes are white blood cells that help defend the body against diseases. They are responsible for the body’s immune response and prevent everyday problems like the common cold, fever, or flu.
According to experts, just one massage is enough to produce enough lymphocytes and measure significant quantifiable changes to the body’s endocrine and immune response.
Did you know that a 45-minute massage increases the number of lymphocytes in the body? Lymphocytes are white blood cells that help defend the body against diseases. They are responsible for the body’s immune response and prevent everyday problems like the common cold, fever, or flu.
According to experts, just one massage is enough to produce enough lymphocytes and measure significant quantifiable changes to the body’s endocrine and immune response.
5. Mobilises lymphatic circulation
The body’s lymphatic system is as important as the body’s blood flow. The lymphatic system is the body’s drainage or sewerage system and responsible for the removal of toxins to keep the body’s fluid balanced and better able to defend against infections. While blood has the heart to pump it throughout the body, the lymphatic system has no such “pump” to force its movement. Movement only occurs when you breathe and contract muscles. When you live a sedentary lifestyle, lymph fluid tends to collect in the body causing toxins to build up which lead to inflammation. The massage action of massage chairs in the reclined position stimulates the lymphatic system and helps to move lymph through the body, combating inflammation and disease. This position also elevates the feet above the heart which is common solution to reduce swelling.
The massage action of massage chairs in the reclined position stimulates the lymphatic system and helps to move lymph through the body, combating inflammation and disease. This position also elevates the feet above the heart which is common solution to reduce swelling.
6. Alleviate pain and headaches
 Massage chairs have a proven track record of alleviating all sorts of pain including headaches, common body aches, chronic neck, shoulder or back pain and more. Studies show that massage therapy decreases cortisol levels (the stress hormone) and increases serotonin by an average of 28%. Serotonin is the body’s feel good hormone and one of the body’s anti-pain mechanisms. By lowering cortisol and increasing serotonin, the body is better able to manage pain.
While most, if not all massage chairs have the potential to ease regular pain, specialised massage chairs are designed to do so. Pain is relieved through a variety of massage programs and body-heating action.
Testimonies from pain sufferers have shown that massage chairs either significantly reduced chronic pain or have eliminated it completely. This is a great benefit for an ageing population or people who may be managing chronic pain. Massage chairs offer a cheaper alternative to expensive physical therapies and gadgets.
For people who have been suffering from pain for a long time, this is the most compelling of all massage chair benefits.
Massage chairs have a proven track record of alleviating all sorts of pain including headaches, common body aches, chronic neck, shoulder or back pain and more. Studies show that massage therapy decreases cortisol levels (the stress hormone) and increases serotonin by an average of 28%. Serotonin is the body’s feel good hormone and one of the body’s anti-pain mechanisms. By lowering cortisol and increasing serotonin, the body is better able to manage pain.
While most, if not all massage chairs have the potential to ease regular pain, specialised massage chairs are designed to do so. Pain is relieved through a variety of massage programs and body-heating action.
Testimonies from pain sufferers have shown that massage chairs either significantly reduced chronic pain or have eliminated it completely. This is a great benefit for an ageing population or people who may be managing chronic pain. Massage chairs offer a cheaper alternative to expensive physical therapies and gadgets.
For people who have been suffering from pain for a long time, this is the most compelling of all massage chair benefits.
7. Decompresses and improves spine alignment
This particular health benefit can be obtained from massage chairs that recline or that feature Zero Gravity. Some premium massage chairs also have massage programs that are designed to align the spine. The Galaxy Dual Core for example, has a dual movement of the rail system to enable a longer stretch and a greater arch whilst promoting the ultimate Thai stretch massage technique.8. Improves posture
Improving overall posture and balance is another benefit of using a massage chair for 20-30 minutes a day. With continued use, a premium massage chair can correct misalignments of the spine, neck and shoulder muscles. That’s why they are popular among actors and sports stars.9. Generates more flexibility
Another benefit of regular massage chair use is increased flexibility. Massage chairs can help combat decreased flexibility caused by a trigger point. A trigger point is a painful condition from overexertion and strenuous exercise that leads to sore muscles and a restricted range of motion. Have you ever played sports or lifted weights so hard that you literally can’t raise your arms after? People suffering from trigger points and spasm areas experience relief and restoration from regular massage therapy. Tense muscles and ‘knots’ are loosened over time.
Research findings from the Buck Institute for Research on Aging in Ontario showed that massage decreases inflammation and even promotes the growth of new mitochondria, the body’s powerhouse on a cellular level.
People suffering from trigger points and spasm areas experience relief and restoration from regular massage therapy. Tense muscles and ‘knots’ are loosened over time.
Research findings from the Buck Institute for Research on Aging in Ontario showed that massage decreases inflammation and even promotes the growth of new mitochondria, the body’s powerhouse on a cellular level.
10. Regulates high blood pressure
 The feeling of total relaxation and wellbeing helps to keep blood pressure down. Similar to the effects of finishing a good run or a yoga workout, your blood pressure lowers, and your heart rate slows after a massage. We can go on about how the body responds to lower blood pressure, but the best proof is to get on a massage chair and experience the “total relaxation” experience.
The feeling of total relaxation and wellbeing helps to keep blood pressure down. Similar to the effects of finishing a good run or a yoga workout, your blood pressure lowers, and your heart rate slows after a massage. We can go on about how the body responds to lower blood pressure, but the best proof is to get on a massage chair and experience the “total relaxation” experience.
11. Improves sleep quality
Studies have shown that massage therapy reduces fatigue and helps you to have a restful and rejuvenating sleep. Quality sleep is essential for restoration. For people who have chronic health conditions such as cancer, heart disease, or psychiatric disorders, massage helps to reduce the stress and worry of the condition allowing a restful night’s sleep which is necessary for healing. Massage helps to release serotonin, our natural feel good hormone which in turn regulates the level of melatonin in your body, the essential hormone for a good night’s sleep.
12. Reduces the incidence of depression
Massage therapy has long been discovered to increase all the happy hormones which include serotonin, dopamine, and endorphins. In studies of women with Stages 1 and 2 breast cancer, it was found that women who had a 30-minute massage, three times a week for five consecutive weeks, reduced feelings of depression and agitation. Their urine results also showed increased levels of dopamine, serotonin, NK cells, and lymphocytes. Not only did their overall mood improve, but their immune systems also received a boost.
According to research, adults who have a 15-minute session in a massage chair twice a week, every week for five consecutive weeks experienced an increase in delta waves and a decrease in alpha waves.
Delta waves are the deep sleep waves while alpha waves are the waking and reasoning waves. Massage chair therapy helped the adults fall into either a deep relaxation state or a light sleeping state while decreasing conscious anxiety.
In studies of women with Stages 1 and 2 breast cancer, it was found that women who had a 30-minute massage, three times a week for five consecutive weeks, reduced feelings of depression and agitation. Their urine results also showed increased levels of dopamine, serotonin, NK cells, and lymphocytes. Not only did their overall mood improve, but their immune systems also received a boost.
According to research, adults who have a 15-minute session in a massage chair twice a week, every week for five consecutive weeks experienced an increase in delta waves and a decrease in alpha waves.
Delta waves are the deep sleep waves while alpha waves are the waking and reasoning waves. Massage chair therapy helped the adults fall into either a deep relaxation state or a light sleeping state while decreasing conscious anxiety.

A wellness boost, on-demand, 24×7
Bring wellness and luxury into your home at an affordable price. Alleviate stress and tension. Improve your mental and emotional health in just 30 minutes a day. Massage chairs are no longer a premium and luxury item. They have become a part of the décor for many Australian homes. We have a range of premium luxury massage chairs to suit your needs and your budget. Talk to us about our finance plans.Feel Good Massage Chairs offers the best range of massage chair products. We can also help you choose the best with our comparison tool. Shop now!
